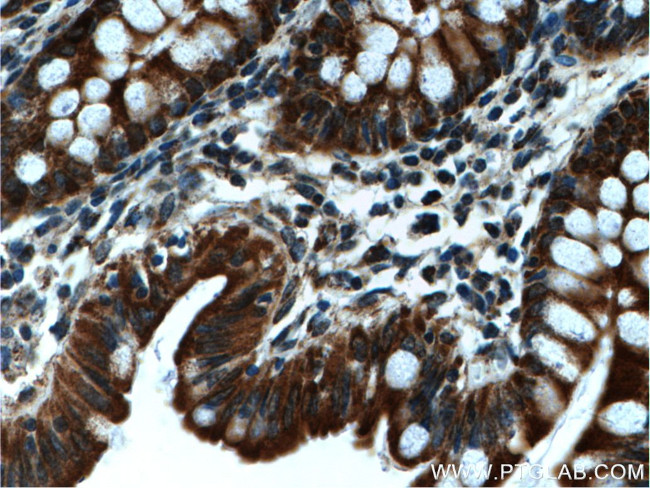
WNK4 Antibody in Immunohistochemistry (Paraffin) (IHC (P))

Search
Proteintech
WNK4 Polyclonal Antibody
{{$productOrderCtrl.translations['antibody.pdp.commerceCard.promotion.promotions']}}
{{$productOrderCtrl.translations['antibody.pdp.commerceCard.promotion.viewpromo']}}
{{$productOrderCtrl.translations['antibody.pdp.commerceCard.promotion.promocode']}}: {{promo.promoCode}} {{promo.promoTitle}} {{promo.promoDescription}}. {{$productOrderCtrl.translations['antibody.pdp.commerceCard.promotion.learnmore']}}
产品信息
22326-1-AP
种属反应
宿主/亚型
分类
类型
抗原
偶联物
形式
浓度
规格
纯化类型
保存液
内含物
保存条件
运输条件
产品详细信息
Immunogen sequence: PISSQVSSN PSPHPTSSPL PFSSSTPEFP VPLSQCPWSS LPTTSPPTFS PTCSQVTLSS PFFPPCPSTS SFPSTTAAPL LSLASAFSLA VMTVAQSLLS PSPGLLSQSP PAPPSPLPSL PLPPPVAPGG QESPSPHTAE VESEASPPPA RPLPGEARLA PISEEGKPQL VGRFQVTSSK EPAEPLPLQP TSPTLSGSPK PSTPQLTSES SDTEDSAGGG PETREALAES DRAAEGLGAG VEEEGDDGKE PQVGGSPQPL SHPSPVWMNY SYSSLCLSSE ESESSGEDEE FWAELQSLRQ KHLSEVETLQ TLQKKEIEDL YSRLGKQPPP GIVAPAAMLS SRQRRLSKGS FPTSRRNSLQ RSEPPGPGIM RRNSLSGSST GSQEQRASKG VTFAGDVGRM (845-1243 aa encoded by BC136664)
靶标信息
This gene encodes a member of the WNK family of serine-threonine protein kinases. The kinase is part of the tight junction complex in kidney cells, and regulates the balance between NaCl reabsorption and K(+) secretion. The kinase regulates the activities of several types of ion channels, cotransporters, and exchangers involved in electrolyte flux in epithelial cells. Mutations in this gene result in pseudohypoaldosteronism type IIB.
仅用于科研。不用于诊断过程。未经明确授权不得转售。
生物信息学
蛋白别名: Protein kinase lysine-deficient 4; Protein kinase with no lysine 4; protein kinase, lysine deficient 4; RP23-281C18.8; Serine/threonine-protein kinase WNK4; unnamed protein product
基因别名: 2010002J11Rik; PHA2B; PRKWNK4; WNK4
UniProt ID: (Human) Q96J92, (Mouse) Q80UE6
Entrez Gene ID: (Human) 65266, (Mouse) 69847